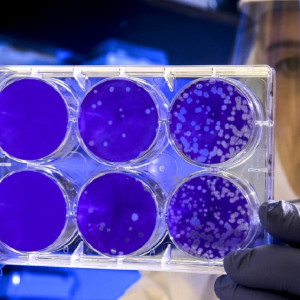
Владимирские санврачи назвали города с максимальным приростом COVID-19

Владимирские санврачи назвали города с максимальным приростом COVID-19
Речь о Владимире и Коврове.
Речь о Владимире и Коврове.

Загорелся один из балконов.

Строители будут восстанавливать участок Кирова и Крупской.

Ярослав не выходил на связь 4 ноября.

Владимир Д. не выходит на связь с 3 ноября.

Для съема зарплата должна быть 80 тыс. рублей.

Программу поддержки продлили до 2026 года.

Разработка заняла первое место на всероссийской научной конференции.

Ответы на главные вопросы – в нашем гайде.

Водители перестали получать ковидные выплаты.

Причиной стало ДТП.

Здание должны были демонтировать еще в 2014 году.

Регион занял 27 строчку.

Ограничения связаны с ремонтом теплосетей.

Пострадавших нет.

Его действия попали под уголовную статью.

Это – первый в регионе мобильный пункт.

Власти проверяют сообщение.

Их получат те, кто проживал в регионе временно.

Мужчина подал в суд на городскую администрацию.